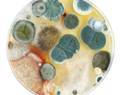
mycologue

Les métiers
De Abatteur à Zoothérapeute en passant par Machiniste...

Métiers liés : Assistant·e opérateur·rice de prise de vues, Camera·wo·man, Directeur·rice de la photographie, Régisseur·euse de spectacles.

Métier lié : Coffreur·euse.





Métiers liés :
Accessoiriste, Magasinier·ère automobile,
E-logisticien·ne,
Livreur·euse/



Métiers liés : Clown, Improvisateur·rice, Magicothérapeute, Marionnettiste, ventriloque, Mime.

Métier lié : Sommelier·ère.


Métiers liés : Agent·e de gardiennage, Agent·e de la Protection civile, Comportementaliste animalier·ère, Dompteur·euse, dresseur·euse d’animaux, Inspecteur·rice de police, Moniteur·rice de chiens-guides, Policier·ère à la brigade canine.




Métiers liés : Educateur·rice sportif·ive, Professeur·e d'éducation physique.


Métiers liés : Conservateur·rice animalier·ère, Ethologue.

Métiers liés : Directeur·rice administratif·ive et financier·ère, Gérant·e-directeur·rice de magasin, Gérant·e de boutique de vêtements, Gérant·e de magasin de tissus, Supply chain manager.


Métiers liés : Acteur·rice, Directeur·rice d’agence de mannequins.

Métiers liés : Coiffeur·euse, Esthéticien·ne, Poseur·euse d'ongles et de cils.


Métiers liés :
Esthéticien·ne,
Technicien·ne des effets spéciaux /

Métiers liés : Responsable des ventes, Vendeur·euse ambulant·e.

Métiers liés : Chargé·e de commerce extérieur, Poissonnier·ère.

Métiers liés : Acteur·rice, Conteur·euse, Magicien·ne, Mime.

Métiers liés : Cordonnier·ère, Couturier·ère, Gantier·ère, Styliste, Tanneur·euse.

Métiers liés : Décorateur·rice de meubles, Ebéniste, Finisseur·euse sur bois, Restaurateur·rice d'art, Restaurateur·rice de meubles, Tourneur·euse sur bois.

Métiers liés : Balnéothérapeute, Esthéticien·ne, Massothérapeute.

Métiers liés : Kinésithérapeute, Masseur·euse, Naturopathe, Ostéopathe, Réflexologue.

Métier lié : Sous-officier·ère détecteur·rice.



Métiers liés : Opérateur·rice de travaux subaquatiques, Sous-officier·ère plongeur·euse-démineur·euse.



Métiers liés : Matelot·e de navigation intérieure et rhénane, Sous-officier·ère service nautique.



Métier lié : Sous-officier·ère transmission maritime.



Métiers liés : Batelier·ère, Matelot service nautique, Patron·ne de pêche.



Métiers liés : Biostatisticien·ne, Chercheur·euse en mathématiques pures ou appliquées, Mathématicien·ne analyste financier·ère, Mathématicien·ne informaticien·ne, Statisticien·ne.

Métiers liés : Actuaire, Chercheur·euse en mathématiques pures ou appliquées, Mathématicien·ne analyste de données, Mathématicien·ne analyste financier·ère, Statisticien·ne.

Métiers liés : Astrophysicien·ne, Chercheur·euse en mathématiques pures ou appliquées.

Métiers liés : Chercheur·euse en mathématiques pures ou appliquées, Cryptographe, cryptanalyste, Informaticien·ne.

Métiers liés : Accessoiriste, Magasinier·ère automobile, Ajusteur·euse-mécanicien·ne ferroviaire, Carrossier·ère, Contrôleur·euse technique de véhicules motorisés, Dépanneur·euse-remorqueur·euse routier·ère, Expert·e automobile, Installateur·rice-monteur·euse automobile, Monteur·euse-réparateur·rice de vitrage automobile, Monteur·euse en pneumatiques, Mécanicien·ne de cycles, Mécanicien·ne de cyclomoteurs et motocyclettes, Mécanicien·ne de poids lourds, Mécanicien·ne naval·e, Réparateur·rice-restaurateur·rice de véhicules anciens, Technicien·ne de maintenance en aéronautique, Technicien·ne en instruments de bord.




Métiers liés : Installateur·rice-monteur·euse automobile, Monteur·euse en pneumatiques, Mécanicien·ne automobile, Mécanicien·ne de cyclomoteurs et motocyclettes, Mécanicien·ne de poids lourds, Réparateur·rice-restaurateur·rice de véhicules anciens.



Métiers liés : Installateur·rice-monteur·euse automobile, Monteur·euse en pneumatiques, Mécanicien·ne automobile, Mécanicien·ne de cycles, Mécanicien·ne de poids lourds, Réparateur·rice-restaurateur·rice de véhicules anciens.



Métier lié : Mécanicien·ne-automaticien·ne.

Métiers liés : Installateur·rice-monteur·euse automobile, Monteur·euse en pneumatiques, Mécanicien·ne automobile, Mécanicien·ne de cycles, Mécanicien·ne de cyclomoteurs et motocyclettes, Réparateur·rice-restaurateur·rice de véhicules anciens.



Métier lié : Mécanicien·ne de poids lourds.




Métiers liés : Mécanicien·ne-automaticien·ne, Mécanicien·ne-régleur·euse de machines textiles, Mécanicien·ne automobile, Mécanicien·ne d'entretien, Mécanicien·ne de chantier, Mécanicien·ne de machines agricoles, Mécanicien·ne de maintenance, Mécanicien·ne de petits moteurs, Mécanicien·ne de poids lourds, Mécanicien·ne industriel·le.


Métier lié : Mécanicien·ne de maintenance.




Métiers liés : Conducteur·rice de machines de fabrication textile, Conducteur·rice de machines de filature textile, Conducteur·rice de machines d’ennoblissement textile, Mécanicien·ne-automaticien·ne, Mécanicien·ne de maintenance, Mécanicien·ne industriel·le.

Métier lié : Médecin spécialiste en médecine physique et réadaptation.





Métier lié : Médecin généraliste.



Métiers liés : Médecin du sport, Médecin du travail, Médecin gériatre, Médecin spécialiste en radiodiagnostic, Médecin spécialiste en radiothérapie-oncologie, Médecin urgentiste, Phytothérapeute, Psychiatre, Tabacologue.





Métier lié : Médecin spécialiste en médecine interne.




Métier lié : Médecin généraliste.





Métiers liés : Médecin spécialiste en radiothérapie-oncologie, Oncologue médical·e.





Métiers liés : Ergothérapeute, Kinésithérapeute, Médecin du sport.





Métiers liés : Médecin spécialiste en médecine nucléaire, Médecin spécialiste en radiothérapie-oncologie, Oncologue médical·e.





Métiers liés : Expert·e en radiophysique médicale, Oncologue médical·e.





Métiers liés : Anesthésiste - réanimateur·rice, Infirmier·ère spécialisé·e en soins intensifs et aide médicale urgente (SIAMU), Médecin spécialiste en médecine interne.




Métiers liés : Chef·fe de produit, Media planner, Strategic planner.

Métiers liés : Media buyer, Strategic planner.

Métiers liés : Assistant·e social·e, Conseiller·ère conjugal·e et familial·e, Conseiller·ère social·e, Ecrivain·e public·que, Médiateur·rice culturel·le, Médiateur·rice interculturel·le, Médiateur·rice scolaire, Psychologue.


Métiers liés : Agent·e des forêts, Débardeur·euse.

Métiers liés : Charpentier·ère, Coffreur·euse, Constructeur·rice de maisons en bois, Ebéniste, Encadreur·euse, Finisseur·euse sur bois, Opérateur·rice en scierie, Restaurateur·rice de meubles, Vitrier·ère.





Métiers liés : Céramiste, Doreur·euse, Soudeur·euse.

Métiers liés : Cartographe, Climatologue, Géochimiste, Géographe, Géologue, Géologue d’exploitation des ressources naturelles, Géologue d’exploration des ressources naturelles, Géophysicien·ne, Météorologiste aéronautique, Photogrammètre, Prévisionniste pour l’annonce des crues, Sismologue, Volcanologue.

Métier lié : Deviseur·euse.




Métiers liés : Administrateur·rice de compagnies, Auteur·e dramatique, dramaturge, Réalisateur·rice, Scénographe.

Métier lié :
Responsable de la production en industrie brassicole - maître brasseur/

Métiers liés : Bactériologiste, Biologiste, chercheur·euse en biologie, Chercheur·euse en biotechnologie, Immunologiste, Mycologue, Parasitologiste, Virologiste.

Métiers liés : Sous-Officier·ère Air Mission Support « Air intel », Sous-Officier·ère Air Mission Support « Air Ops », Sous-Officier·ère Air Mission Support « Flight Sim Operator », Sous-Officier·ère Air Mission Support « Mission Planning ».



Métiers liés : Contrôleur·euse aérien·ne, Officier·ère Air Traffic Control.



Métier lié : Sous-Officier·ère Artilleur·euse.



Métier lié : Sous-Officier·ère combat-manœuvre.


Métier lié : Sous-officier·ère para-commando.



Métiers liés : Pompier·ère, Pompier·ère d'aéroport, Sous-officier·ère pompier·ère d’aérodrome.



Métiers liés : Acteur·rice, Clown, Conteur·euse, Danseur·euse, Humoriste, imitateur·rice, Improvisateur·rice, Magicien·ne, Marionnettiste, ventriloque.

Métiers liés : Gemmologue, Géochimiste, Géologue, Géologue d’exploitation des ressources naturelles, Géologue d’exploration des ressources naturelles, Géophysicien·ne, Géotechnicien·ne, Hydrogéologue, Ingénieur·e des mines et géologue, Ingénieur·e géothermicien·ne, Paléontologue, Pédologue, Sismologue, Spécialiste en dépollution des sols, Volcanologue.

Métiers liés : Cordonnier·ère, Couturier·ère, Maroquinier·ère, Patronnier·ère-gradeur·euse, Styliste.

Métiers liés : Animateur·rice 2D-3D, Architecte, Architecte d'intérieur, Designer, Sculpteur·euse.

Métiers liés : Accessoiriste, ensemblier·ère, Costumier·ère, habilleur·euse, Couturier·ère, Styliste.

Métiers liés : Comportementaliste animalier·ère, Dompteur·euse, dresseur·euse d’animaux, Maître-chien, Policier·ère à la brigade canine.

Métiers liés : Animateur·rice, Coordinateur·rice de centre de vacances, Educateur·rice, Educateur·rice en milieu scolaire.


Métiers liés : Coach sportif·ive, Educateur·rice sportif·ive, Entraîneur·euse sportif·ive, Gestionnaire d'infrastructures sportives, Gestionnaire de salle de fitness, Moniteur·rice fitness, Skippeur·euse, Sportif·ve professionnel·le.

Métiers liés :
Adaptateur·rice,
Bruiteur·euse,
Concepteur·rice vidéo,
Directeur·rice de postproduction,
Technicien·ne des effets spéciaux /


Métiers liés : Charpentier·ère, Charpentier·ère en structures métalliques, Concepteur·rice d'agrès, Couvreur·euse, Monteur·euse en structure bois.


Métiers liés : Couvreur·euse, Electricien·ne, Electricien·ne chargé·e de la maintenance des systèmes solaires photovoltaïques.

Métiers liés : Accessoiriste, Magasinier·ère automobile, Contrôleur·euse technique de véhicules motorisés, Dépanneur·euse-remorqueur·euse routier·ère, Installateur·rice-monteur·euse automobile, Monteur·euse-réparateur·rice de vitrage automobile, Mécanicien·ne automobile, Mécanicien·ne de cycles, Mécanicien·ne de cyclomoteurs et motocyclettes, Mécanicien·ne de poids lourds, Nettoyeur·euse de véhicules motorisés, Réceptionniste de garage automobile, Réparateur·rice-restaurateur·rice de véhicules anciens.

Métier lié : Monteur·euse de chapiteau.

Métiers liés : Dessinateur·rice en électricité, Electricien·ne lignes et réseaux, Inspecteur·rice d'installations électriques.


Métiers liés : Accessoiriste, Magasinier·ère automobile, Contrôleur·euse technique de véhicules motorisés, Dépanneur·euse-remorqueur·euse routier·ère, Installateur·rice-monteur·euse automobile, Monteur·euse en pneumatiques, Mécanicien·ne automobile, Mécanicien·ne de cycles, Mécanicien·ne de cyclomoteurs et motocyclettes, Mécanicien·ne de poids lourds, Nettoyeur·euse de véhicules motorisés, Réceptionniste de garage automobile, Réparateur·rice-restaurateur·rice de véhicules anciens.

Métiers liés : Carreleur·euse, Céramiste, Doreur·euse, Décorateur·rice d'intérieur, Restaurateur·rice d'art, Sculpteur·euse, Tapissier·ère-garnisseur·euse.


Métiers liés : Animateur·rice du patrimoine, Architecte d'intérieur, Commissaire d'exposition, Conservateur·rice du patrimoine, Designer, Décorateur·rice d'intérieur, Galeriste, Historien·ne de l'art, Scénographe.

Métiers liés : Arrangeur·euse, Art-thérapeute, Chef·fe d'orchestre, Compositeur·rice, Compositeur·rice de musique de film, Directeur·rice musical·e, Dj·ette, Musicologue, Professeur·e de musique, Sound designer.

Métiers liés :
Critique musical·e,
Musicien·ne /
Métiers liés : Biochimiste, Biologiste, chercheur·euse en biologie, Biologiste en environnement, Botaniste, Chercheur·euse en biotechnologie, Microbiologiste, Parasitologiste, Toxicologue, écotoxicologue.
























